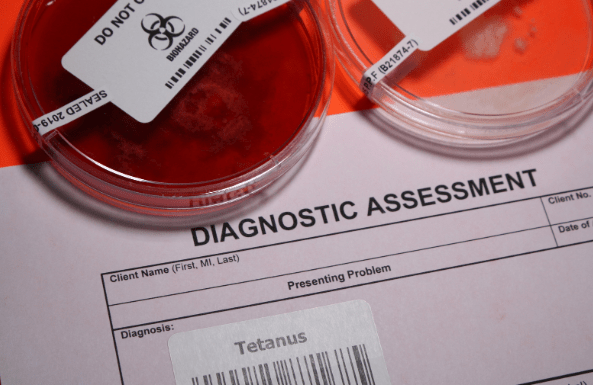

Clostridium tetani is a spore-forming, Gram-positive, anaerobic bacillus that produces neurotoxins after its spores enter the body through wounds. The organism has a drumstick-like appearance and can survive in the external environment for many years. C. tetani produces two toxins: hemolysin and tetanospasmin. Hemolysin is an oxygen-sensitive toxin, whereas tetanospasmin is described as a highly potent neurotoxin.
Unlike humans and horses, dogs are considered to be much more resistant to tetanus toxin. In cats, resistance to the effects of this toxin is reported to be 12 times greater than in dogs. As a result of this natural resistance, the prevalence of tetanus in dogs and cats is relatively low.

Clostridium tetani bacterium
Etiology
Transmission occurs through the entry of resistant Clostridium tetani spores—commonly found in soil rich in organic matter and in the environment—into the body via contaminated wounds. In addition, the umbilical cord is considered one of the primary routes of infection.
Pathophysiology
Contamination of wounds with other bacteria, tissue necrosis, and the presence of foreign bodies create favorable conditions for C. tetani spores to transform into their active form and proliferate. C. tetani is not a bacterium that spreads throughout the tissues; rather, it exerts its effects by producing toxins when an anaerobic environment develops locally. Hemolysin facilitates the production of tetanospasmin, the toxin responsible for the clinical manifestations.
The toxins produced by C. tetani spread to the muscles and reach the lymphatic system, subsequently entering the bloodstream. From there, toxin molecules bind irreversibly to the inhibitory interneurons of the spinal cord and brain. This prevents the release of gamma-aminobutyric acid (GABA) and glycine, which normally inhibit excessive neuronal excitation. The incubation period is usually around one week, though cases with incubation up to three weeks have been reported.
Clinical Presentation
Characteristic localized and generalized muscle rigidity develops within 5–10 days after injury. Due to their natural resistance, cats often show symptoms only after about three weeks.
In dogs, tetanus can be classified into generalized and localized forms, with the localized form being more common. Muscle stiffness initially appears near the wound site where C. tetani entered, and gradually spreads to other extremities and the rest of the body. Thus, localized tetanus may progress into the generalized form.

Image: Extracted from https://youtu.be/EG68o3YbCP4 .
In the generalized form, severe muscle rigidity develops, resulting in a stiff and rigid gait or even an inability to walk. Hyperthermia may occur due to excessive muscular activity. In advanced stages of the disease, protrusion of the third eyelid and enophthalmos may be observed. A wrinkled appearance of the forehead, characteristic ear pricking, and retraction of the lips also develop. Trismus (lockjaw) may occur; however, this symptom arises from hypertonus of the masticatory muscles. Affected animals show heightened sensitivity to auditory and tactile stimuli. Generalized convulsions and opisthotonus are also among the possible clinical signs.

Tetanus (lockjaw) victim. The contracted body of a soldier…
Differential Diagnosis
Muscle contractions and stiffness observed in both the generalized and localized forms are characteristic of tetanus. However, differential diagnosis should consider trauma (particularly those involving the central nervous system), rabies, meningitis-encephalitis, strychnine and lead poisoning, and hypocalcemia.
Diagnosis
Currently, the diagnosis of tetanus primarily relies on wound history and clinical signs. During physical examination, a wound may not always be visible on the skin. Hematological parameters may show a neutrophilic left shift. In animals with generalized muscle contractions, creatine kinase levels may be particularly elevated. The presence of serum antibody titers against the toxin is one of the diagnostic methods, although its use is limited. C. tetani can be directly isolated from the wound site, but this method is not generally recommended.
Treatment
Once clinical signs appear, intensive supportive care is required until the symptoms are resolved. Hospitalization may be necessary for 3–4 weeks in animals with the generalized form. Treatment may include:
- Supportive care
- Antitoxin therapy
- Muscle relaxation
- Antimicrobial therapy
- Surgical intervention
“For more detailed information regarding treatment, consultation with a veterinarian is recommended.”
Prevention
Tetanus toxoid can be used, but it is primarily administered in animals with acute onset. Routine vaccination is generally not required in cats and dogs due to their natural resistance to the disease.

This blog has been verified by Dr. Vet. Hek. Begüm MAŞLAK.
Resources:
İstanbul University- Cerrahpaşa Faculty of Veterinary Medicine, Pathology Nervous System Pathology Lecture Slides.
SCHAER, M. GASCHEN, F. (2019) Köpek ve Kedilerin Klinik Hekimliği. Konya, Türkiye: Nuri ALTUĞ, Last accessed: 22.03.2024





Yorum bırakın